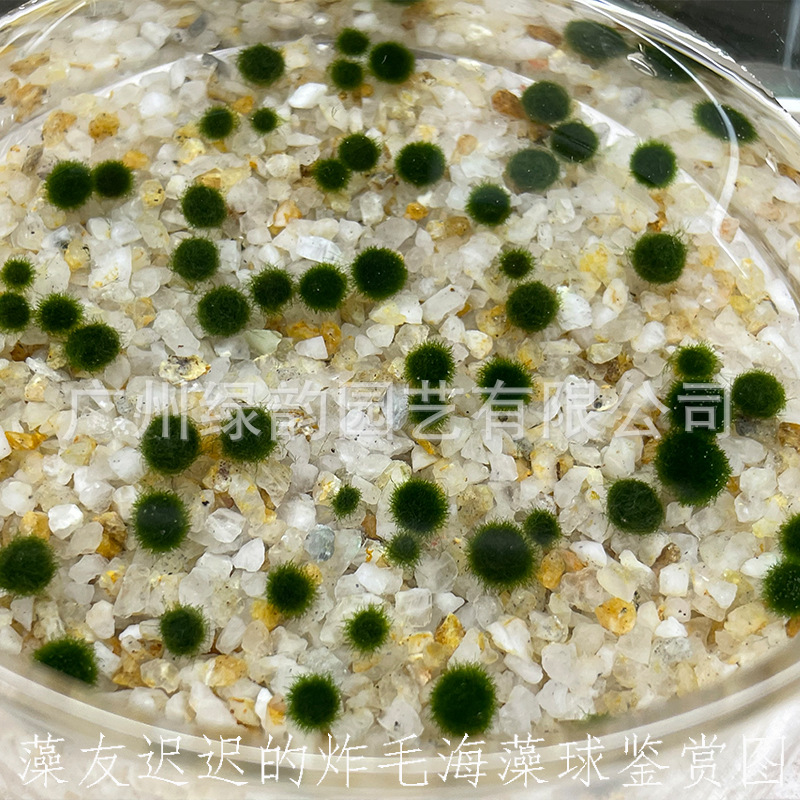

Marimo счастливый шар из морских водорослей декоративные живые настоящие водные растения оптом микропейзаж эко бутылка аквариум незеленый шарик из водорослей
Продано за 30 дней:
11761 шт.
Всего продаж:
1929351 шт.
Минимальное количество для заказа:
1 шт.
Marimo счастливый шар из морских водорослей декоративные живые настоящие водные растения оптом микропейзаж эко бутылка аквариум незеленый шарик из водорослей
от 7.67 ₽ за 1 шт.
-21%
7.67 ₽
Доставка по Китаю включена в цену
Оптом
от 1 шт.
7.67 ₽
Описание












Характеристики
Происхождение:
Гуанчжоу
Номер артикла:
Мяч из морских водорослей
Импорт или нет:
Нет
Водные растения и удобрения:
Мяч из морских водорослей
Функции:
Красивый
Бренд:
Зеленое рифмовное садоводство
Цвет:
0,1 года 1 (0,3 ~ 0.5cm); Полгода (0,9 ~ 1 см); 1 год (1,1 ~ 1.2cm); 2 года (1,2 ~ 1.4cm); 4 года (1.5-1.7cm); 6 лет (2 см); 8 лет (2.2cm); 0,3 года (0,6 ~ 0.8cm); 3 года (1,4 ~ 1.5cm); 6 марта (0,6 ~ 0.8cm); 4 полугода (0,9 ~ 1 см); 1 год 3 (1,1 ~ 1.2cm); 2 года 2 (1,3 ~ 1.4cm); 4 года 2 (1,6-1,8 см); Половина 1 2 года; Половина 1 2 4 года; 1 2 3 года; Ограничение: 0,3 лет 2 (0,6 ~ 0.8cm); 0,1 лет 3; 0,3 года 3
Является ли трансграничный экспорт выделенных источников поставок:
Нет
Стиль:
Японский маримо
Форма:
Круглый (нежареный)
Упаковка:
Мешок
Категории продуктов:
Водная трава
О продавце
Имя:
Оценка предложения:
1.6
Оценка сервиса:
4.0
Оценка споров и жалоб:
5.0
repeatPurchasePercent:
0.6502607029371934
Оценка логистики:
3.2
qualityRefundWithin30Day:
0.0125
afterSalesExperienceScore:
3.6
Оценка консультации:
3.0
collect30DayWithin48HPercent:
0.9130434782608695

Marimo счастливый шар из морских водорослей декоративные живые настоящие водные растения оптом микропейзаж эко бутылка аквариум незеленый шарик из водорослей
7.67 ₽
7.67 ₽